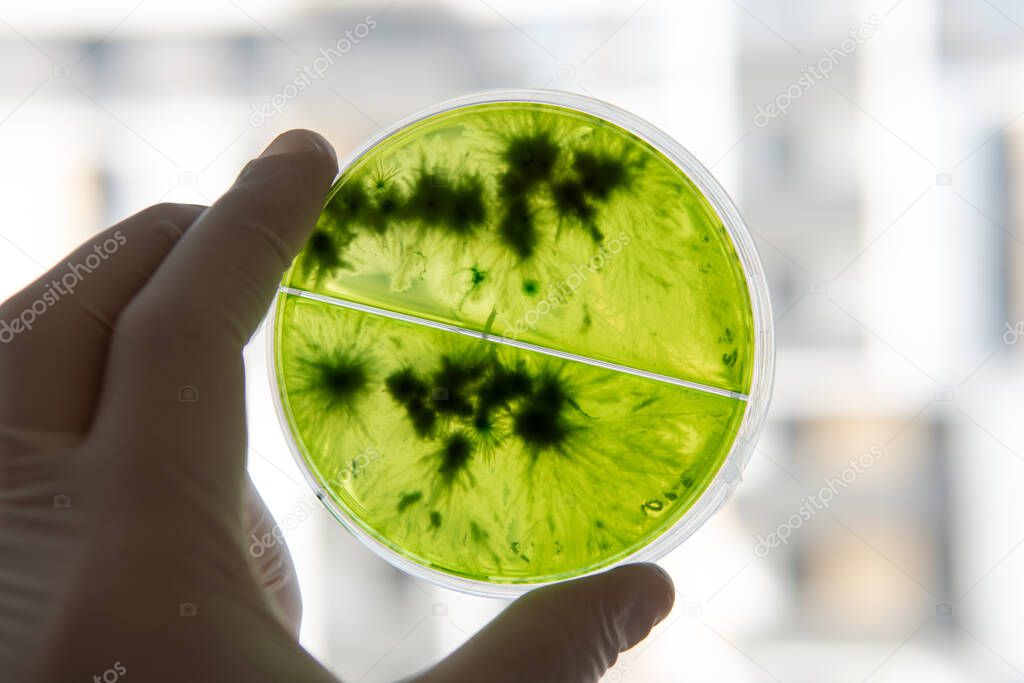
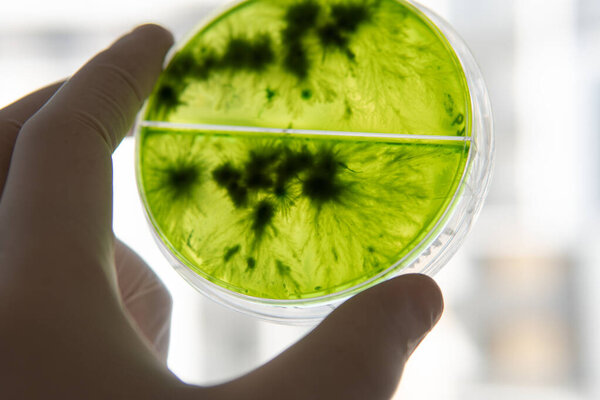
Mycology and conservation of mushroom cultures. Mycelium of the lions mane mushroom, mycelium in a Petri dish. Breeding of mushroom cultures
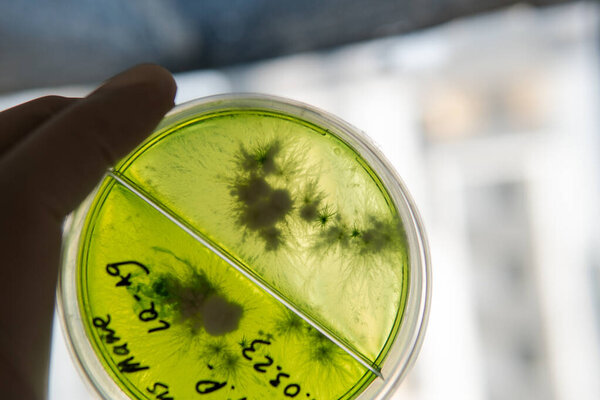
Mycology and conservation of mushroom cultures. Mycelium of the lions mane mushroom, mycelium in a Petri dish. Breeding of mushroom cultures
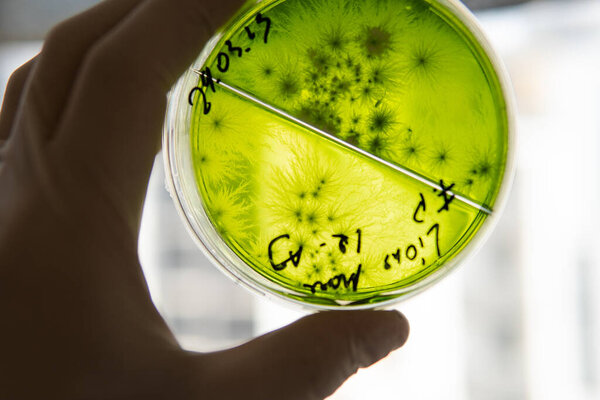
Mycology and conservation of mushroom cultures. Mycelium of the lions mane mushroom, mycelium in a Petri dish. Breeding of mushroom cultures
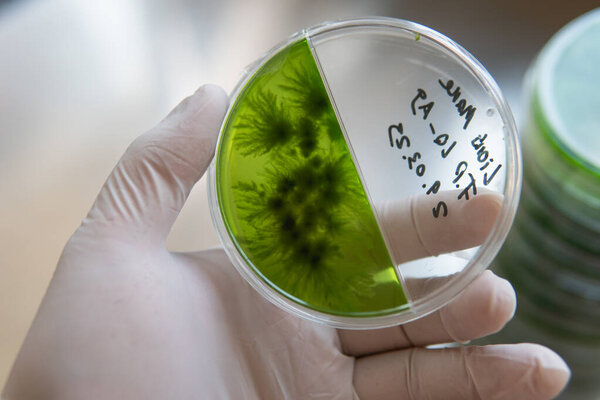
Popular medicinal mushrooms, the beneficial effects of the lions mane mushroom on humans. The future of mushrooms and their role in saving humanity. Petri dish with mycelium of mushroom culture
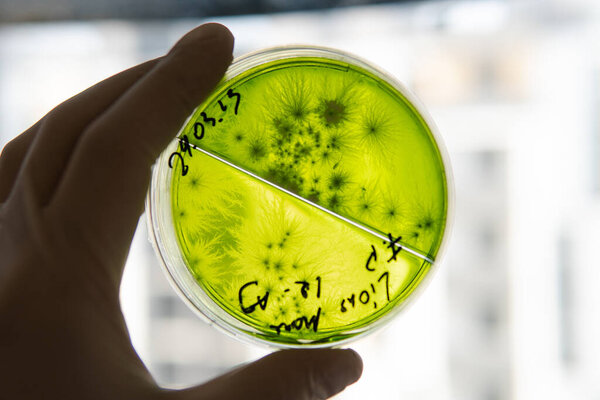
Popular medicinal mushrooms, the beneficial effects of the lions mane mushroom on humans. The future of mushrooms and their role in saving humanity. Petri dish with mycelium of mushroom culture
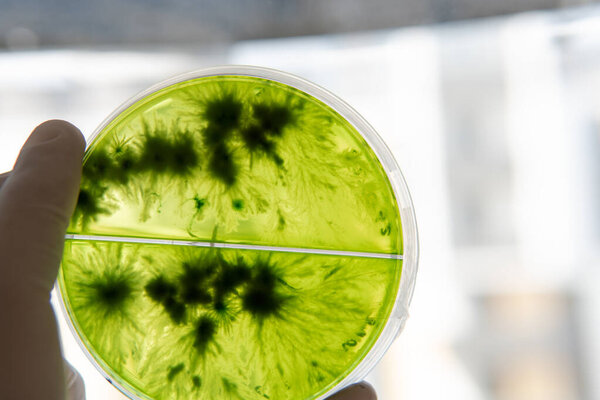
Mycology and conservation of mushroom cultures. Mycelium of the lions mane mushroom, mycelium in a Petri dish. Breeding of mushroom cultures
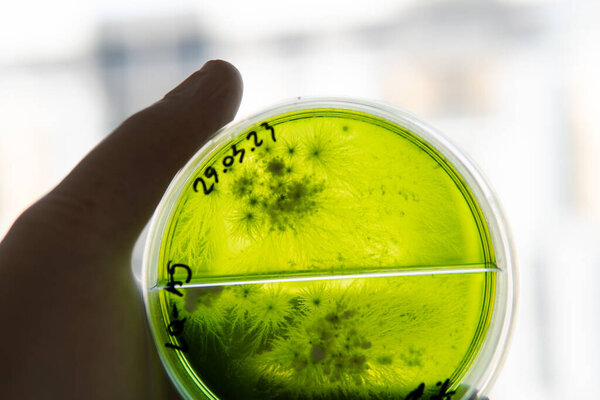
Popular medicinal mushrooms, the beneficial effects of the lions mane mushroom on humans. The future of mushrooms and their role in saving humanity. Petri dish with mycelium of mushroom culture
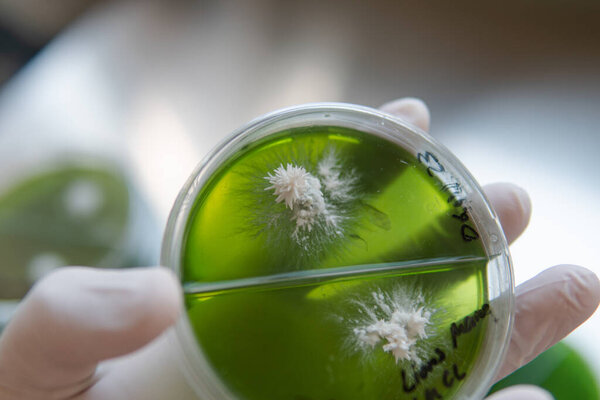
Mycelium selection, cultivation and reservation of mushrooms under laboratory conditions.
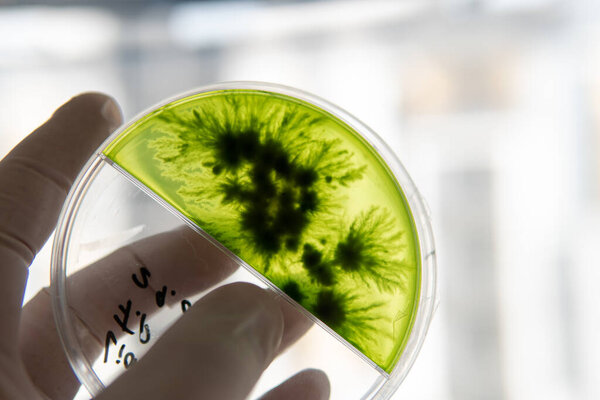
Mycelium selection, cultivation and reservation of mushrooms under laboratory conditions. Medical functional fungi in the modern world

- /
- Search /
- Popular medicinal mushrooms, the beneficial effects of the lions mane mushroom on humans. The future of mushrooms and their role in saving humanity. Petri dish with mycelium of mushroom culture
Popular medicinal mushrooms, the beneficial effects of the lions mane mushroom on humans. The future of mushrooms and their role in saving humanity. Petri dish with mycelium of mushroom culture
Popular medicinal mushrooms, the beneficial effects of the lions mane mushroom on humans. The future of mushrooms and their role in saving humanity. Petri dish with mycelium of mushroom culture
image
image
May.24, 2023 08:28:21
24
0.67
333x500
667x1000
1333x2000
4000x6000
4000x6000
1
1
vasilevkirill
BACKGROUND ISOLATED TRANSPARENT CLOSEUP HEALTH HEALTHY BROWN MEDICINE TECHNOLOGY MUSHROOM PICTURE ACCESSORY PRODUCT CLIP GLASSWARE FUNGUS DISCOVERY MEDICINAL ISOLATES FUNGI MUSHROOMS MYCOLOGY MYCELIUM CULTURES PETRI AGAR ERINACEUS HERICIUM ERINACEUS PETRI DISHES LIONS MANE PETRI DISH ISOLATED TAMPENSIS